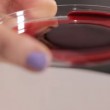
VIDEO YOUTUBE Sangue e veleno di serpente: ecco cosa succede 5

ROMA – Cosa succede se il sangue umano viene a contatto con il veleno di un serpente? A mostrare la reazione pericolosa è un video di Bbc Earth Unplugged caricato su YouTube. Mescolando il sangue umano con il veleno, questo si addensa diventando una sostanza gelatinosa e solida.
D’altronde il veleno di serpente è in grado di creare piccoli coaguli di sangue che si formano proprio all’interno dei vasi sanguigni e che possono causare degli infarti e ostruire la circolazione, portando alla morte della malcapitata vittima del morso. Maddie Moate, ospite della puntata di Bbc Earth Unplugged, ha donato 10 millilitri del proprio sangue e li ha mischiati al veleno di una vipera rostrata-squamata, che vive nell’Asia centrale e in paesi come India, Afghanistan e Iran orientale.
Questo serpente, lungo tra i 40 e i 60 centimetri, è tra i più aggressivi e velenosi al mondo. La vipera rostrata-squamata è considerata una vera e propria “killer” e come il serpente che ha fatto più vittime, considerando la letalità del suo veleno e la sua tendenza a mordere spesso.
Nel video si può vedere il veleno agire sul sangue, causandone una coagulazione molto veloce. Da una iniziale consistenza liquida, il sangue della Moate diventa rapidamente gelatinoso nella provetta usata per l’esperimento. Un incontro ravvicinato, con questo serpente, non si augura a nessuno.